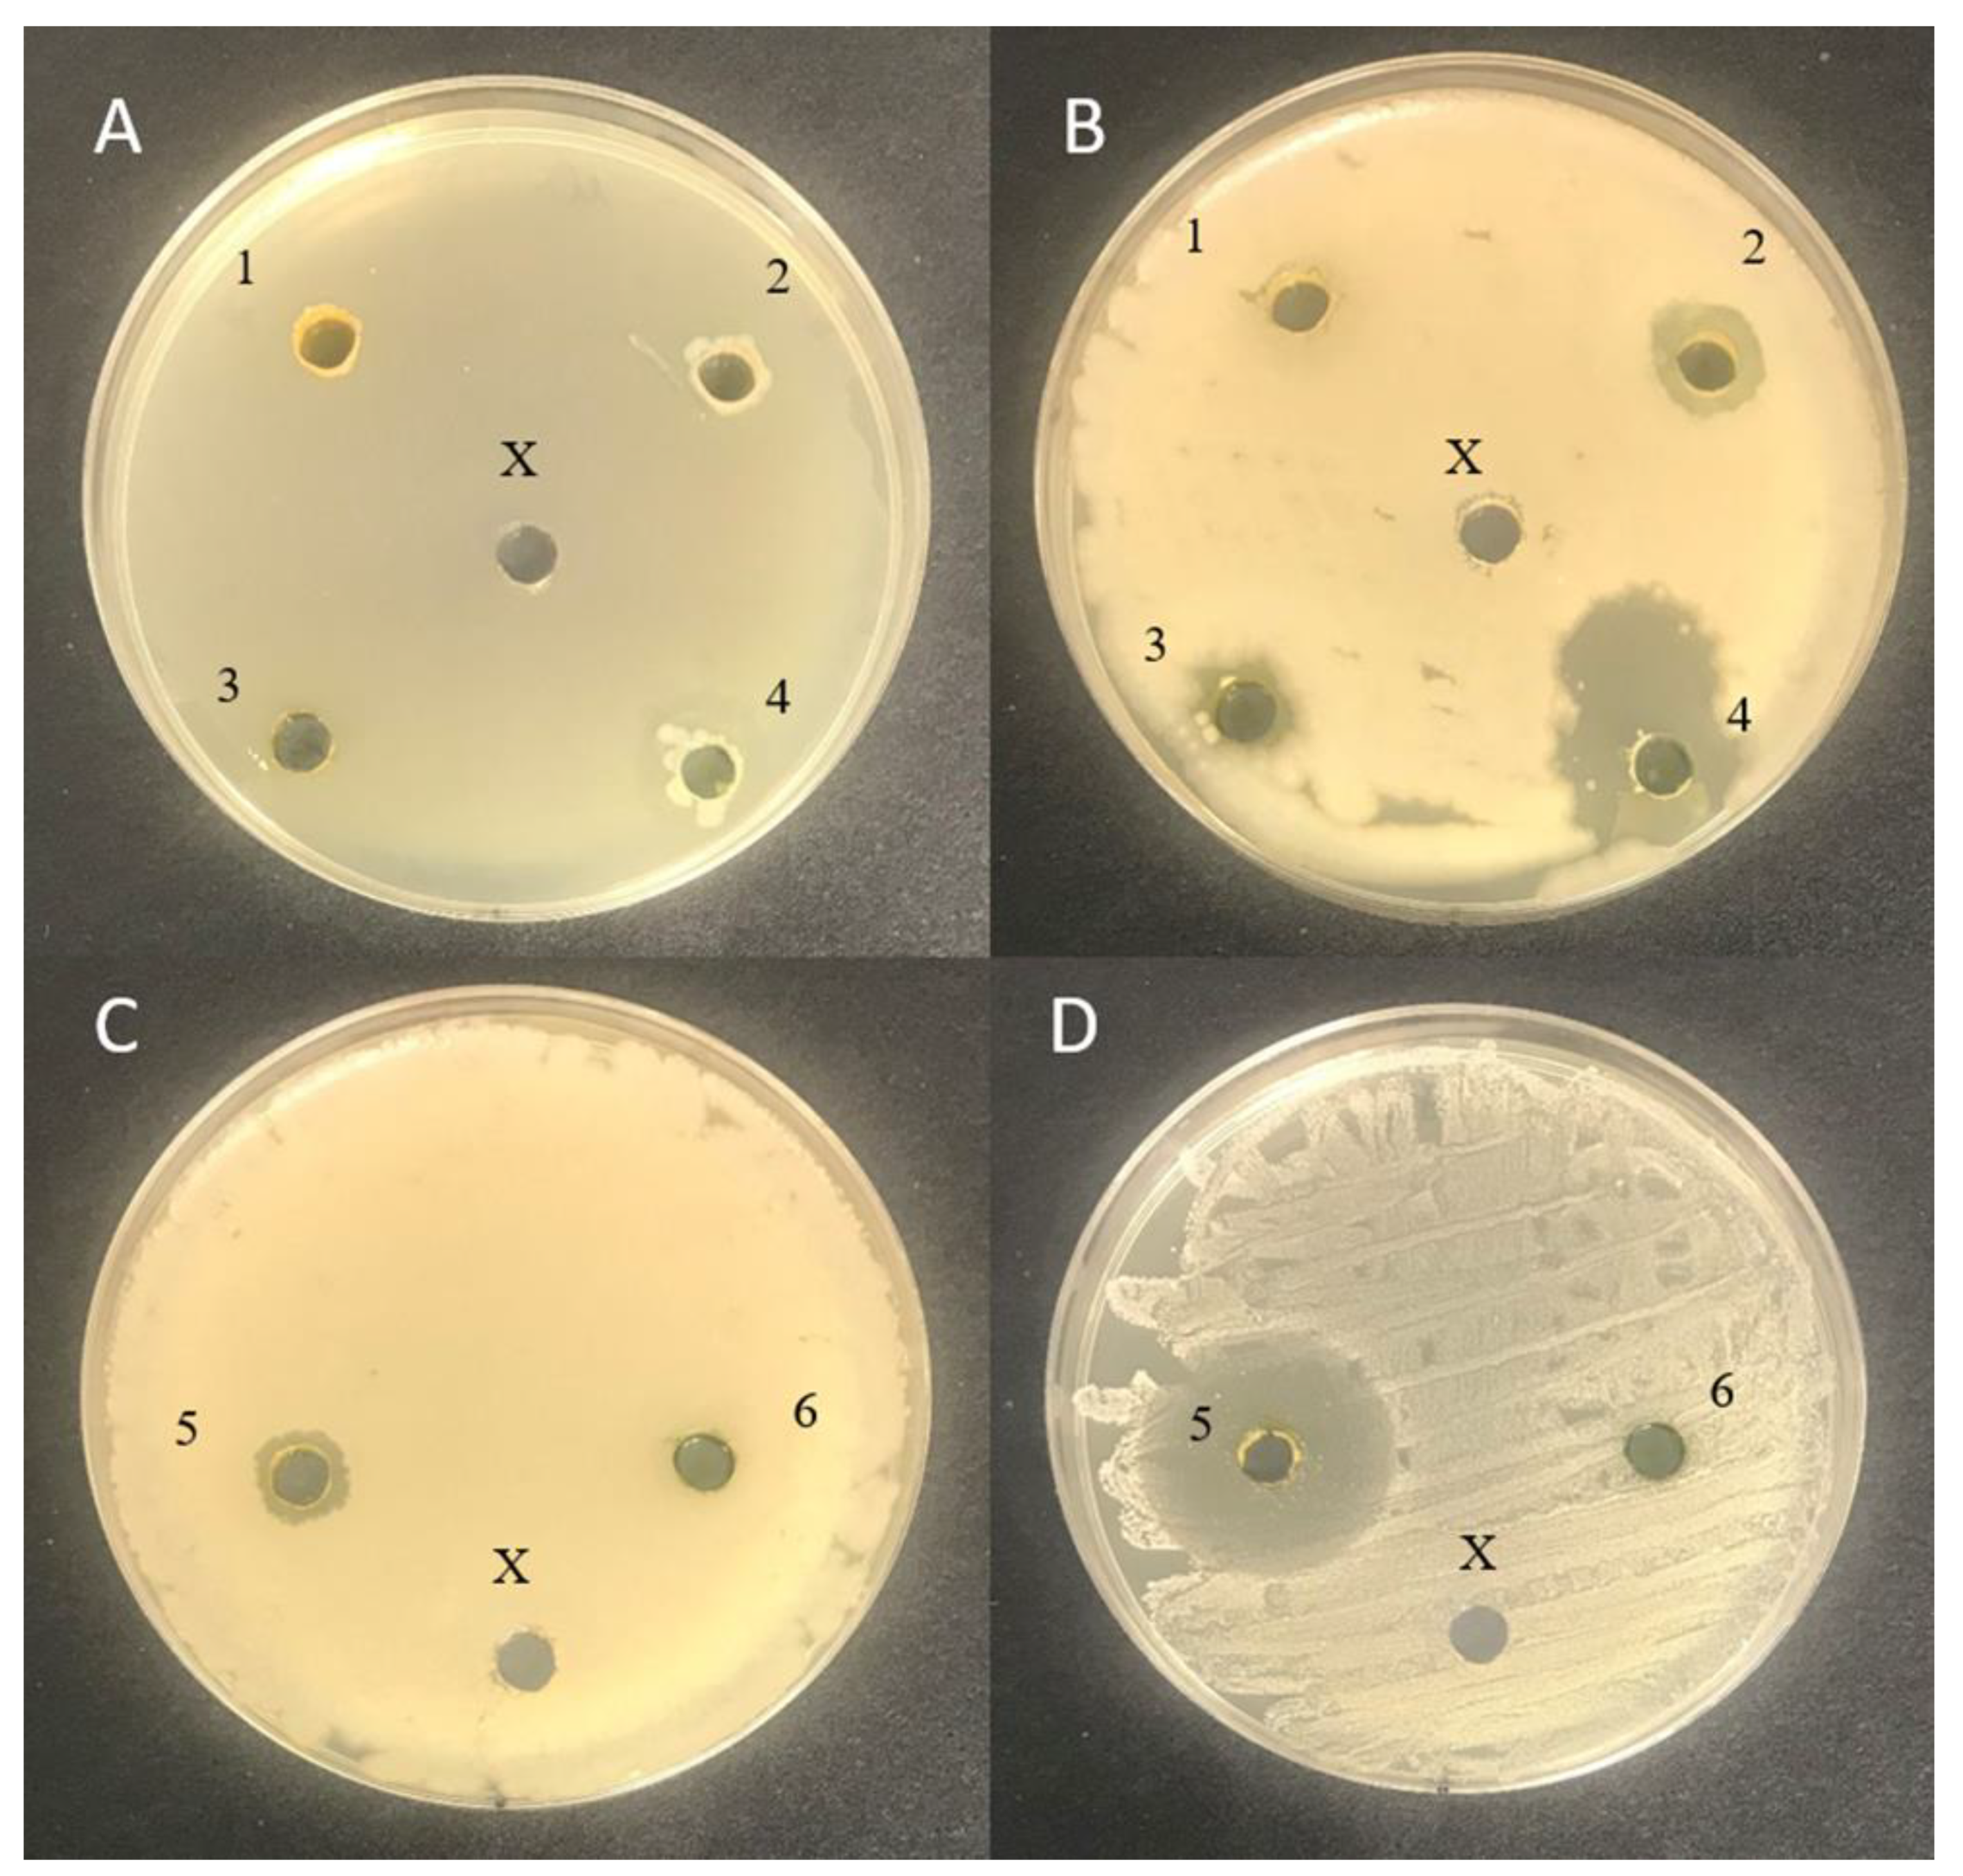

Characterization of Macro- and Microalgae Extracts Bioactive Compounds and Micro- and Macroelements Transition from Algae to Extract
Abstract
:1. Introduction
2. Materials and Methods
2.1. Macro- and Microalgae Samples Used in Experiments
2.2. Chlorophyll a and b and Carotenoid Analysis in Algal Samples
2.3. Preparation of Algal Sample Extracts and Determination of the Total Phenolic Compound Content and Antioxidant Capacity of the Algae Extracts
2.4. Measurement of the Algae Colour Chromaticity Parameters
2.5. Evaluation of the Antimicrobial Activity of the Algal Extract Samples
2.6. Analysis of Micro- and Macroelements in Algal Extract Samples
2.7. Statistical Analysis
3. Results and Discussion
3.1. Total Carotenoid and Chlorophyll a and b Contents in Algal Samples
3.2. Antioxidant Characteristics and Chromaticity Parameters of the Algal Samples
3.3. Antimicrobial Activity of the Algal Extract Samples
3.4. Micro- and Macroelement Concentrations in Algal Samples
4. Conclusions
Supplementary Materials
Author Contributions
Funding
Institutional Review Board Statement
Informed Consent Statement
Data Availability Statement
Conflicts of Interest
References
- Blumberga, D.; Chen, B.; Ozarska, A.; Indzere, Z.; Lauka, D. Energy, Bioeconomy, Climate Changes and Environment Nexus. Environ. Clim. Technol. 2019, 23, 370–392. [Google Scholar] [CrossRef]
- Pastare, L.; Romagnoli, F. Life Cycle Cost Analysis of Biogas Production from, and in Latvian Conditions. Environ. Clim. Technol. 2019, 23, 258–271. [Google Scholar] [CrossRef]
- Zihare, L.; Gusca, J.; Spalvins, K.; Blumberga, D. Priorities Determination of Using Bioresources. Case Study of Heracleum Sosnowskyi. Sci. J. Riga Tech. Univ. Environ. Clim. Technol. 2019, 23, 242–256. [Google Scholar] [CrossRef]
- Díaz-Reinoso, B. Chapter 14—Concentration and purification of seaweed extracts using membrane technologies. In Sustainable Seaweed Technologies; Torres, M.D., Kraan, S., Dominguez, H., Eds.; Advances in Green Chemistry; Elsevier: Amsterdam, The Netherlands, 2020; pp. 371–390. ISBN 978-0-12-817943-7. [Google Scholar]
- Kumar, B.R.; Mathimani, T.; Sudhakar, M.P.; Rajendran, K.; Nizami, A.-S.; Brindhadevi, K.; Pugazhendhi, A. A State of the Art Review on the Cultivation of Algae for Energy and Other Valuable Products: Application, Challenges, and Opportunities. Renew. Sustain. Energy Rev. 2021, 138, 110649. [Google Scholar] [CrossRef]
- Khan, M.N.; Khorshid Abbas, Z. Variation in Photosynthetic Pigments, Antioxidant Enzymes and Osmolyte Accumulation in Seaweeds of Red Sea. Int. J. Plant Biol. Res. 2015. [Google Scholar]
- Nazarudin, M.F.; Isha, A.; Mastuki, S.N.; Ain, N.M.; Mohd Ikhsan, N.F.; Abidin, A.Z.; Aliyu-Paiko, M. Chemical Composition and Evaluation of the α-Glucosidase Inhibitory and Cytotoxic Properties of Marine Algae Ulva Intestinalis, Halimeda Macroloba, and Sargassum Ilicifolium. Evid. Based Complement. Alternat. Med. 2020, 2020, e2753945. [Google Scholar] [CrossRef] [PubMed]
- Michalak, I.; Messyasz, B. Concise Review of Cladophora spp.: Macroalgae of Commercial Interest. J. Appl. Phycol. 2021, 33, 133–166. [Google Scholar] [CrossRef]
- Khuantrairong, T.; Traichaiyaporn, S. The Nutritional Value of Edible Freshwater Alga Cladophora sp. (Chlorophyta) Grown under Different Phosphorus Concentrations. Int. J. Agric. Biol. Pak. 2011, 13, 297–300. [Google Scholar]
- Joyce, K.E.; Phinn, S.R. Hyperspectral Analysis of Chlorophyll Content and Photosynthetic Capacity of Coral Reef Substrates. Limnol. Oceanogr. 2003, 48, 489–496. [Google Scholar] [CrossRef]
- Vega, J.; Álvarez-Gómez, F.; Güenaga, L.; Figueroa, F.L.; Gómez-Pinchetti, J.L. Antioxidant Activity of Extracts from Marine Macroalgae, Wild-Collected and Cultivated, in an Integrated Multi-Trophic Aquaculture System. Aquaculture 2020, 522, 735088. [Google Scholar] [CrossRef]
- Peñuelas, J.; Filella, I. Visible and Near-Infrared Reflectance Techniques for Diagnosing Plant Physiological Status. Trends Plant Sci. 1998, 3, 151–156. [Google Scholar] [CrossRef]
- Kirst, G.O. Salinity Tolerance of Eukaryotic Marine Algae. Annu. Rev. Plant Physiol. Plant Mol. Biol. 1990, 41, 21–53. [Google Scholar] [CrossRef]
- Kotta, J.; Möller, T.; Orav-Kotta, H.; Pärnoja, M. Realized Niche Width of a Brackish Water Submerged Aquatic Vegetation under Current Environmental Conditions and Projected Influences of Climate Change. Mar. Environ. Res. 2014, 102, 88–101. [Google Scholar] [CrossRef] [PubMed]
- Vahtmäe, E.; Kotta, J.; Orav-Kotta, H.; Kotta, I.; Pärnoja, M.; Kutser, T. Predicting Macroalgal Pigments (Chlorophyll a, Chlorophyll b, Chlorophyll a + b, Carotenoids) in Various Environmental Conditions Using High-Resolution Hyperspectral Spectroradiometers. Int. J. Remote Sens. 2018, 39, 5716–5738. [Google Scholar] [CrossRef]
- Yokoya, N.S.; Necchi, O.; Martins, A.P.; Gonzalez, S.F.; Plastino, E.M. Growth Responses and Photosynthetic Characteristics of Wild and Phycoerythrin-Deficient Strains of Hypnea Musciformis (Rhodophyta). J. Appl. Phycol. 2007, 19, 197–205. [Google Scholar] [CrossRef]
- Ji, N.K.; Kumar, R.N.; Bora, A.; Amb, M.K.; Chakraborthy, S. An Evaluation of the Pigment Composition of Eighteen Marine Macroalgae Collected from Okha Coast, Gulf of Kutch, India. Our Nat. 2009, 7, 48–55. [Google Scholar] [CrossRef]
- Heriyanto, H.; Juliadiningtyas, A.; Shioi, Y.; Limantara, L.; Brotosudarmo, T. Analysis of Pigment Composition of Brown Seaweeds Collected from Panjang Island, Central Java, Indonesia. Philipp. J. Sci. 2017, 146, 323–330. [Google Scholar]
- Rinawati, M.; Sari, L.A.; Pursetyo, K.T. Chlorophyll and Carotenoids Analysis Spectrophotometer Using Method on Microalgae. In Proceedings of the IOP Conference Series: Earth and Environmental Science, Surabaya, Indonesia, 26 September 2019; Volume 441, p. 012056. [Google Scholar] [CrossRef]
- Fernando, I.P.S.; Kim, M.; Son, K.-T.; Jeong, Y.; Jeon, Y.-J. Antioxidant Activity of Marine Algal Polyphenolic Compounds: A Mechanistic Approach. J. Med. Food 2016, 19, 615–628. [Google Scholar] [CrossRef] [PubMed]
- Souza, B.W.S.; Cerqueira, M.A.; Bourbon, A.I.; Pinheiro, A.C.; Martins, J.T.; Teixeira, J.A.; Coimbra, M.A.; Vicente, A.A. Chemical Characterization and Antioxidant Activity of Sulfated Polysaccharide from the Red Seaweed Gracilaria Birdiae. Food Hydrocoll. 2012, 27, 287–292. [Google Scholar] [CrossRef]
- Torres, P.; Santos, J.P.; Chow, F.; Pena Ferreira, M.J.; dos Santos, D.Y.A.C. Comparative Analysis of in Vitro Antioxidant Capacities of Mycosporine-like Amino Acids (MAAs). Algal Res. 2018, 34, 57–67. [Google Scholar] [CrossRef]
- Amsler, C.D.; Fairhead, V.A. Defensive and Sensory Chemical Ecology of Brown Algae; Elsevier Academic Press: Amsterdam, The Netherlands, 2006. [Google Scholar]
- Jormalainen, V.; Honkanen, T. Macroalgal Chemical Defenses and Their Roles in Structuring Temperate Marine Communities. In Algal Chemical Ecology; Amsler, C.D., Ed.; Springer: Berlin/Heidelberg, Germany, 2008; pp. 57–89. ISBN 978-3-540-74181-7. [Google Scholar]
- Pavia, H.; Toth, G.B. Influence of Light and Nitrogen on the Phlorotannin Content of the Brown Seaweeds Ascophyllum Nodosum and Fucus Vesiculosus. Hydrobiologia 2000, 440, 299–305. [Google Scholar] [CrossRef]
- Sobhan, R.; Sternberg, S.P.K. Cadmium Removal Using Cladophora. J. Environ. Sci. Health Part A 1999, 34, 53–72. [Google Scholar] [CrossRef]
- Bačkorová, M.; Maslaňáková, I.; Bačkor, M. Copper Uptake and Copper-Induced Physiological Changes in the Marine Alga Cladophora Prolifera (Roth.) Kütz. (Chlorophyta, Ulvophyceae). Braz. J. Bot. 2016, 39, 447–452. [Google Scholar] [CrossRef]
- Ebadi, A.G.; Hisoriev, H. The Prevalence of Heavy Metals in Cladophora glomerata L. from Farahabad Region of Caspian Sea—Iran. Toxicol. Environ. Chem. 2017, 99, 883–891. [Google Scholar] [CrossRef]
- Zbikowski, R.; Szefer, P.; Latała, A. Comparison of Green Algae Cladophora sp. and Enteromorpha sp. as Potential Biomonitors of Chemical Elements in the Southern Baltic. Sci. Total Environ. 2007, 387, 320–332. [Google Scholar] [CrossRef] [PubMed]
- Akın, H.K.; Ünlü, E. Cadmium Accumulation by Green Algae Cladophora glomerata (L.) Kutz. (Chlorophyta) in Presence of Nile Tilapia Oreochromis niloticus (L.). Toxicol. Environ. Chem. 2013, 95, 1565–1571. [Google Scholar] [CrossRef]
- Tolpeznikaite, E.; Ruzauskas, M.; Pilkaityte, R.; Bartkevics, V.; Zavistanaviciute, P.; Starkute, V.; Lele, V.; Zokaityte, E.; Mozuriene, E.; Ruibys, R.; et al. Influence of Fermentation on the Characteristics of Baltic Sea Macroalgae, Including Microbial Profile and Trace Element Content. Food Control 2021, 129, 108235. [Google Scholar] [CrossRef]
- Horincar, V.; Parfene, G.; Tyagi, A.; Gottardi, D.; Dinică, R.; Guerzoni, M.E.; Bahrim, G. Extraction and Characterization of Volatile Compounds and Fatty Acids from Red and Green Macroalgae from the Romanian Black Sea in Order to Obtain Valuable Bioadditives and Biopreservatives. J. Appl. Phycol. 2013, 26, 551–559. [Google Scholar] [CrossRef]
- Lezcano, V.; Fernández, C.; Parodi, E.R.; Morelli, S. Antitumor and Antioxidant Activity of the Freshwater Macroalga Cladophora Surera. J. Appl. Phycol. 2018, 30, 2913–2921. [Google Scholar] [CrossRef]
- Munir, M.; Qureshi, R.; Bibi, M.; Khan, A.M. Pharmaceutical Aptitude of Cladophora: A Comprehensive Review. Algal Res. 2019, 39, 101476. [Google Scholar] [CrossRef]
- Soltani, S.; Ebrahimzadeh, M.A.; Khoshrooei, R.; Rahmani, Z. Antibacterial and Antihemolytic Activities of Enteromorpha Intestinalis in Caspian Sea Coast, Iran. J. Med. Plants Res. 2012, 6, 530–533. [Google Scholar] [CrossRef]
- Srimaroeng, C.; Ontawong, A.; Saowakon, N.; Vivithanaporn, P.; Pongchaidecha, A.; Amornlerdpison, D.; Soodvilai, S.; Chatsudthipong, V. Antidiabetic and Renoprotective Effects of Cladophora Glomerata Kützing Extract in Experimental Type 2 Diabetic Rats: A Potential Nutraceutical Product for Diabetic Nephropathy. J. Diabetes Res. 2015, 2015, 320167. [Google Scholar] [CrossRef]
- Zbakh, H.; Chiheb, I.; Motilva, V.; Riadi, H. Antibacterial, Cytotoxic and Antioxidant Potentials of Cladophora prolifera (Roth) Kutzing Collected from the Mediterranean Coast of Morocco. Am. J. Phytomedicine Clin. Ther. 2014, 2, 1187–1199. [Google Scholar]
- Torres-Tiji, Y.; Fields, F.J.; Mayfield, S.P. Microalgae as a Future Food Source. Biotechnol. Adv. 2020, 41, 107536. [Google Scholar] [CrossRef]
- Dere, S.; Güneş, T.; Sivaci, R. Spectrophotometric Determination of Chlorophyll-A, B and Total Carotenoid Contents of Some Algae Species Using Different Solvents. Turk. J. Bot. 1998, 22, 13–17. [Google Scholar]
- Sakalauskaitė, J.; Viskelis, P.; Dambrauskienė, E.; Sakalauskienė, S.; Samuolienė, G.; Brazaitytė, A.; Duchovskis, P.; Urbonavičienė, D. The Effects of Different UV-B Radiation Intensities on Morphological and Biochemical Characteristics in Ocimum basilicum L. J. Sci. Food Agric. 2013, 93, 1266–1271. [Google Scholar] [CrossRef] [PubMed]
- Nayek, S.; Haque, C.I.; Nishika, J.; Roy, S. Spectrophotometric Analysis of Chlorophylls and Carotenoids from Commonly Grown Fern Species by Using Various Extracting Solvents. Res. J. Chem. Sci. 2014, 4, 2231–2606. [Google Scholar] [CrossRef]
- Ainsworth, E.A.; Gillespie, K.M. Estimation of Total Phenolic Content and Other Oxidation Substrates in Plant Tissues Using Folin-Ciocalteu Reagent. Nat. Protoc. 2007, 2, 875–877. [Google Scholar] [CrossRef] [PubMed]
- Brand-Williams, W.; Cuvelier, M.E.; Berset, C. Use of a Free Radical Method to Evaluate Antioxidant Activity. LWT Food Sci. Technol. 1995, 28, 25–30. [Google Scholar] [CrossRef]
- Urbonaviciene, D.; Viskelis, P.; Viškelis, J.; Jankauskiene, J.; Bobinas, C. Lycopene and β-Carotene in Non-Blanched and Blanched Tomatoes. J. Food Agric. Environ. 2012, 10, 142–146. [Google Scholar] [CrossRef]
- Benzie, I.F.; Strain, J.J. The Ferric Reducing Ability of Plasma (FRAP) as a Measure of “Antioxidant Power”: The FRAP Assay. Anal. Biochem. 1996, 239, 70–76. [Google Scholar] [CrossRef] [PubMed]
- Bobinaitė, R.; Pataro, G.; Lamanauskas, N.; Šatkauskas, S.; Viškelis, P.; Ferrari, G. Application of Pulsed Electric Field in the Production of Juice and Extraction of Bioactive Compounds from Blueberry Fruits and Their By-Products. J. Food Sci. Technol. 2015, 52, 5898–5905. [Google Scholar] [CrossRef] [PubMed]
- Bartkiene, E.; Bartkevics, V.; Starkute, V.; Krungleviciute, V.; Cizeikiene, D.; Zadeike, D.; Juodeikiene, G.; Maknickiene, Z. Chemical Composition and Nutritional Value of Seeds of Lupinus luteus L., L. angustifolius L. and New Hybrid Lines of L. angustifolius L. Zemdirb. Agric. 2016, 103, 107–116. [Google Scholar] [CrossRef]
- Gille, A.; Trautmann, A.; Posten, C.; Briviba, K. Bioaccessibility of Carotenoids from Chlorella Vulgaris and Chlamydomonas Reinhardtii. Int. J. Food Sci. Nutr. 2016, 67, 507–513. [Google Scholar] [CrossRef] [PubMed]
- Cha, K.H.; Lee, H.J.; Koo, S.Y.; Song, D.-G.; Lee, D.-U.; Pan, C.-H. Optimization of Pressurized Liquid Extraction of Carotenoids and Chlorophylls from Chlorella Vulgaris. J. Agric. Food Chem. 2010, 58, 793–797. [Google Scholar] [CrossRef] [PubMed]
- Kitada, K.; Machmudah, S.; Sasaki, M.; Goto, M.; Nakashima, Y.; Kumamoto, S.; Hasegawa, T. Supercritical CO2 Extraction of Pigment Components with Pharmaceutical Importance from Chlorella Vulgaris. J. Chem. Technol. Biotechnol. 2009, 84, 657–661. [Google Scholar] [CrossRef]
- Zhang, H.; Huang, D.; Cramer, W.A. Stoichiometrically Bound Beta-Carotene in the Cytochrome B6f Complex of Oxygenic Photosynthesis Protects against Oxygen Damage. J. Biol. Chem. 1999, 274, 1581–1587. [Google Scholar] [CrossRef]
- Tavanandi, H.A.; Vanjari, P.; Raghavarao, K.S.M.S. Synergistic Method for Extraction of High Purity Allophycocyanin from Dry Biomass of Arthrospira Platensis and Utilization of Spent Biomass for Recovery of Carotenoids. Sep. Purif. Technol. 2019, 225, 97–111. [Google Scholar] [CrossRef]
- Chuyen, H.V.; Eun, J.-B. Marine Carotenoids: Bioactivities and Potential Benefits to Human Health. Crit. Rev. Food Sci. Nutr. 2017, 57, 2600–2610. [Google Scholar] [CrossRef]
- Zhang, J.; Sun, Z.; Sun, P.; Chen, T.; Chen, F. Microalgal Carotenoids: Beneficial Effects and Potential in Human Health. Food Funct. 2014, 5, 413–425. [Google Scholar] [CrossRef]
- Tavanandi, H.A.; Raghavarao, K.S.M.S. Recovery of Chlorophylls from Spent Biomass of Arthrospira Platensis Obtained after Extraction of Phycobiliproteins. Bioresour. Technol. 2019, 271, 391–401. [Google Scholar] [CrossRef]
- Christwardana, M.; Nur, M.M.A.; Hadiyanto, H. Spirulina Platensis: Potensinya sebagai bahan pangan fungsional. J. Apl. Teknol. Pangan 2013, 2. [Google Scholar]
- Hagerthey, S.E.; Louda, J.W.; Mongkronsri, P. Evaluation of pigment extraction methods and a recommended protocol for periphyton chlorophyll a determination and chemotaxonomic assessment1. J. Phycol. 2006, 42, 1125–1136. [Google Scholar] [CrossRef]
- European Food Safety Authority. Scientific Opinion on the Re-Evaluation of Chlorophylls (E 140(i)) as Food Additives. EFSA J. 2015. [Google Scholar] [CrossRef]
- Yilmaz, C.; Gökmen, V. Chlorophyll. In Encyclopedia of Food and Health; Academic Press: Cambridge, MA, USA, 2016; Volume 2, pp. 37–41. [Google Scholar]
- Faulks, R.; Southon, S. Dietary Carotenoids. Nutr. Food Sci. 1997, 97, 246–250. [Google Scholar] [CrossRef]
- Urbonavičienė, D.; Bobinas, Č.; Bobinaitė, R.; Raudonė, L.; Trumbeckaitė, S.; Viškelis, J.; Viškelis, P. Composition and Antioxidant Activity, Supercritical Carbon Dioxide Extraction Extracts, and Residue after Extraction of Biologically Active Compounds from Freeze-Dried Tomato Matrix. Processes 2021, 9, 467. [Google Scholar] [CrossRef]
- Meléndez-Martínez, A.J.; Mandić, A.I.; Bantis, F.; Böhm, V.; Borge, G.I.A.; Brnčić, M.; Bysted, A.; Cano, M.P.; Dias, M.G.; Elgersma, A.; et al. A Comprehensive Review on Carotenoids in Foods and Feeds: Status Quo, Applications, Patents, and Research Needs. Crit. Rev. Food Sci. Nutr. 2021, 1–51. [Google Scholar] [CrossRef]
- Bogacz-Radomska, L.; Harasym, J.; Piwowar, A. 10—Commercialization aspects of carotenoids. In Carotenoids: Properties, Processing and Applications; Galanakis, C.M., Ed.; Academic Press: Cambridge, MA, USA, 2020; pp. 327–357. ISBN 978-0-12-817067-0. [Google Scholar]
- Shahidi, F.; Zhong, Y. Novel Antioxidants in Food Quality Preservation and Health Promotion. Eur. J. Lipid Sci. Technol. 2010, 112, 930–940. [Google Scholar] [CrossRef]
- Shahidi, F.; Ambigaipalan, P. Phenolics and Polyphenolics in Foods, Beverages and Spices: Antioxidant Activity and Health Effects—A Review. J. Funct. Foods 2015, 18, 820–897. [Google Scholar] [CrossRef]
- Santoso, J.; Yoshie, Y.; Suzuki, T. Polyphenolic compounds from seaweeds: Distribution and their antioxidative effect. In Developments in Food Science; Sakaguchi, M., Ed.; More Efficient Utilization of Fish and Fisheries Products; Elsevier: Amsterdam, The Netherlands, 2004; Volume 42, pp. 169–177. [Google Scholar]
- Wang, T.; Jónsdóttir, R.; Ólafsdóttir, G. Total Phenolic Compounds, Radical Scavenging and Metal Chelation of Extracts from Icelandic Seaweeds. Food Chem. 2009, 116, 240–248. [Google Scholar] [CrossRef]
- Messyasz, B.; Pikosz, M.; Treska, E. Biology of Freshwater Macroalgae and Their Distribution. In Algae Biomass: Characteristics and Applications: Towards Algae-Based Products; Chojnacka, K., Wieczorek, P.P., Schroeder, G., Michalak, I., Eds.; Developments in Applied Phycology; Springer International Publishing: Cham, Switzerland, 2018; pp. 17–31. ISBN 978-3-319-74703-3. [Google Scholar]
- Karan, T.; Erenler, R. Fatty Acid Constituents and Anticancer Activity of Cladophora Fracta (OF Müller Ex Vahl) Kützing. Trop. J. Pharm. Res. 2018, 17, 1977–1982. [Google Scholar] [CrossRef]
- Zarei Jeliani, Z.; Mashjoor, S.; Soleimani, S.; Pirian, K.; Sedaghat, F.; Yosefzadi, M. Antioxidant Activity and Cytotoxicity of Organic Extracts from Three Species of Green Macroalgae of Ulvaceae from Persian Gulf. Modares J. Biotechnol. 2018, 9, 59–67. [Google Scholar]
- Srikong, W.; Bovornreungroj, N.; Mittraparparthorn, P.; Bovornreungroj, P. Antibacterial and Antioxidant Activities of Differential Solvent Extractions from the Green Seaweed Ulva Intestinalis. ScienceAsia 2017, 43, 88–95. [Google Scholar] [CrossRef]
- Farasat, M.; Khavari-Nejad, R.-A.; Nabavi, S.M.B.; Namjooyan, F. Antioxidant Activity, Total Phenolics and Flavonoid Contents of Some Edible Green Seaweeds from Northern Coasts of the Persian Gulf. Iran. J. Pharm. Res. 2014, 13, 163–170. [Google Scholar] [PubMed]
- Tepe, B.; Daferera, D.; Sokmen, A.; Sokmen, M.; Polissiou, M. Antimicrobial and Antioxidant Activities of the Essential Oil and Various Extracts of Salvia Tomentosa Miller (Lamiaceae). Food Chem. 2005, 90, 333–340. [Google Scholar] [CrossRef]
- Naczk, M.; Shahidi, F. Phenolics in Cereals, Fruits and Vegetables: Occurrence, Extraction and Analysis. J. Pharm. Biomed. Anal. 2006, 41, 1523–1542. [Google Scholar] [CrossRef] [PubMed]
- Naseri, A.; Holdt, S.L.; Jacobsen, C. Biochemical and Nutritional Composition of Industrial Red Seaweed Used in Carrageenan Production. J. Aquat. Food Prod. Technol. 2019, 28, 967–973. [Google Scholar] [CrossRef]
- Sabeena Farvin, K.H.; Jacobsen, C. Phenolic Compounds and Antioxidant Activities of Selected Species of Seaweeds from Danish Coast. Food Chem. 2013, 138, 1670–1681. [Google Scholar] [CrossRef]
- Tibbetts, S.M.; Milley, J.E.; Lall, S.P. Nutritional Quality of Some Wild and Cultivated Seaweeds: Nutrient Composition, Total Phenolic Content and in Vitro Digestibility. J. Appl. Phycol. 2016, 28, 3575–3585. [Google Scholar] [CrossRef]
- Taghavi Takyar, M.B.; Haghighat Khajavi, S.; Safari, R. Evaluation of Antioxidant Properties of Chlorella Vulgaris and Spirulina Platensis and Their Application in Order to Extend the Shelf Life of Rainbow Trout (Oncorhynchus Mykiss) Fillets during Refrigerated Storage. LWT 2019, 100, 244–249. [Google Scholar] [CrossRef]
- Agregán, R.; Munekata, P.E.S.; Franco, D.; Carballo, J.; Barba, F.J.; Lorenzo, J.M. Antioxidant Potential of Extracts Obtained from Macro- (Ascophyllum Nodosum, Fucus Vesiculosus and Bifurcaria Bifurcata) and Micro-Algae (Chlorella Vulgaris and Spirulina Platensis) Assisted by Ultrasound. Medicines 2018, 5, E33. [Google Scholar] [CrossRef] [PubMed]
- Chakraborty, K.; Lipton, A.P.; Paul Raj, R.; Vijayan, K.K. Antibacterial Labdane Diterpenoids of Ulva Fasciata Delile from Southwestern Coast of the Indian Peninsula. Food Chem. 2010, 119, 1399–1408. [Google Scholar] [CrossRef]
- Schweder, T.; Lindequist, U.; Lalk, M. Screening for New Metabolites from Marine Microorganisms. In Marine Biotechnology I.; Ulber, R., Le Gal, Y., Eds.; Advances in Biochemical Engineering/Biotechnology; Springer: Berlin/Heidelberg, Germany, 2005; Volume 96, pp. 1–48. ISBN 978-3-540-25659-5. [Google Scholar]
- Newman, D.J.; Cragg, G.M.; Snader, K.M. Natural Products as Sources of New Drugs over the Period 1981-2002. J. Nat. Prod. 2003, 66, 1022–1037. [Google Scholar] [CrossRef] [PubMed]
- Dussault, D.; Vu, K.D.; Vansach, T.; Horgen, F.D.; Lacroix, M. Antimicrobial Effects of Marine Algal Extracts and Cyanobacterial Pure Compounds against Five Foodborne Pathogens. Food Chem. 2016, 199, 114–118. [Google Scholar] [CrossRef]
- Kandhasamy, M.; Arunachalam, K.D. Evaluation of in Vitro Antibacterial Property of Seaweeds of Southeast Coast of India. Afr. J. Biotechnol. 2008, 7. [Google Scholar] [CrossRef]
- Pesando, D.; Caram, B. Screening of Marine Algae from the French Mediterranean Coast for Antibacterial and Antifungal Activity. Botanica Marina. 1984, 27, 381–386. [Google Scholar] [CrossRef]
- Priyadharshini, S.; Bragadeeswaran, S.; Prabhu, K.; Ran, S.S. Antimicrobial and Hemolytic Activity of Seaweed Extracts Ulva Fasciata (Delile 1813) from Mandapam, Southeast Coast of India. Asian Pac. J. Trop. Biomed. 2011, 1, S38–S39. [Google Scholar] [CrossRef]
- Ibtissam, C.; Hassane, R.; José, M.-L.; Seglar, D.; Francisco, J.; Vidal, G.; Antonio, J.; Bouziane, H.; Kadiri, M. Screening of Antibacterial Activity in Marine Green and Brown Macroalgae from the Coast of Morocco. Afr. J. Biotechnol. 2010, 8, 1258–1262. [Google Scholar]
- Lustigman, B.; Brown, C. Antibiotic Production by Marine Algae Isolated from the New York/New Jersey Coast. Bull. Environ. Contam. Toxicol. 1991, 46, 329–335. [Google Scholar] [CrossRef]
- Manilal, A.; Sujith, S.; Sabarathnam, B.; Kiran, G.S.; Selvin, J.; Shakir, C.; Lipton, A.P. Bioactivity of the Red Algae Asparagopsis Taxiformis Collected from the Southwestern Coast of India. Braz. J. Oceanogr. 2010, 58, 93–100. [Google Scholar] [CrossRef]
- Kumar, K.A.; Rengasamy, R. Evaluation of Antibacterial Potential of Seaweeds Occurring along the Coast of Tamil Nadu, India against the Plant Pathogenic Bacterium Xanthomonas Oryzae Pv. Oryzae (Ishiyama) Dye. J. Coast. Life Med. 2000, 43, 409–415. [Google Scholar] [CrossRef]
- Patra, A.K.; Acharya, B.C.; Mohapatra, A. Occurrence and Distribution of Bacterial Indicators and Pathogens in Coastal Waters of Orissa. IJMS 2009, 38, 474–480. [Google Scholar]
- Salvador, N.; Garreta, A.G.; Lavelli, L.; Ribera, M.A. Antimicrobial Activity of Iberian Macroalgae. Sci. Mar. 2007, 71, 101–114. [Google Scholar] [CrossRef]
- Vallinayagam, K.; Arumugam, R.; Kannan, R.; Thirumaran, G.; Anantharaman, P. Antibacterial Activity of Seaweeds of Pudumadam Coast. Glob. J. Pharmacol. 2009, 3, 50–52. [Google Scholar]
- Bennett, P.M. Plasmid Encoded Antibiotic Resistance: Acquisition and Transfer of Antibiotic Resistance Genes in Bacteria. Br. J. Pharmacol. 2008, 153, S347–S357. [Google Scholar] [CrossRef]
- Fischbach, M.A.; Walsh, C.T. Antibiotics for Emerging Pathogens. Science 2009, 325, 1089–1093. [Google Scholar] [CrossRef] [PubMed]
- Kiran, N.; Siddiqui, G.; Khan, A.N.; Khan, I.; Pavase, T. Extraction and Screening of Bioactive Compounds with Antimicrobial Properties from Selected Species of Mollusk and Crustacean. J. Clin. Cell Immunol. 2014, 5, 1–5. [Google Scholar] [CrossRef]
- Lee, K.-A.; Moon, S.H.; Kim, K.-T.; Mendonca, A.F.; Paik, H.-D. Antimicrobial Effects of Various Flavonoids on Escherichia coli O157:H7 Cell Growth and Lipopolysaccharide Production. Food Sci. Biotechnol. 2010, 19, 257–261. [Google Scholar] [CrossRef]
- Li, X.-Z.; Nikaido, H. Efflux-Mediated Drug Resistance in Bacteria. Drugs 2009, 69, 1555–1623. [Google Scholar] [CrossRef]
- Stix, G. An Antibiotic Resistance Fighter. Sci. Am. 2006, 294, 80–83. [Google Scholar] [CrossRef]
- Wright, G.D.; Sutherland, A.D. New Strategies for Combating Multidrug-Resistant Bacteria. Trends Mol. Med. 2007, 13, 260–267. [Google Scholar] [CrossRef]
- Rizwan, S.; Siddiqui, G.; Shoaib, M.; Mahmood, K.; Ul-Hassan, H. Antibacterial Activity of Ulva Intestinalis, U. Faciata, and U. Lactuca against Biofilm-Associated Bacteria. Egypt. J. Aquat. Biol. Fish. 2020, 24, 669–676. [Google Scholar] [CrossRef]
- Shoaib, M.; Burhan, Z.-N.; Shafique, S.; Jabeen, H.; Jamal, P.; Siddique, A. Phytoplankton Composition in a Mangrove Ecosystem at Sandspit, Karachi, Pakistan. Pak. J. Bot 2017, 49, 379–387. [Google Scholar]
- Hellio, C.; Bremer, G.; Pons, A.M.; Le Gal, Y.; Bourgougnon, N. Inhibition of the Development of Microorganisms (Bacteria and Fungi) by Extracts of Marine Algae from Brittany, France. Appl. Microbiol. Biotechnol. 2000, 54, 543–549. [Google Scholar] [CrossRef] [PubMed]
- Lima-Filho, J.V.M.; Carvalho, A.F.F.U.; Freitas, S.M.; Melo, V.M.M. Antibacterial Activity of Extracts of Six Macroalgae from the Northeastern Brazilian Coast. Braz. J. Microbiol. 2002, 33, 311–314. [Google Scholar] [CrossRef]
- Moreau, J.; Pesando, D.; Bernard, P.; Caram, B.; Pionnat, J.C. Seasonal Variations in the Production of Antifungal Substances by Some Dictyotales (Brown Algae) from the French Mediterranean Coast. Hydrobiologia 1988, 162, 157–162. [Google Scholar] [CrossRef]
- Osman, M.E.H.; Abushady, A.M.; Elshobary, M.E. In Vitro Screening of Antimicrobial Activity of Extracts of Some Macroalgae Collected from Abu-Qir Bay Alexandria, Egypt. Afr. J. Biotechnol. 2010, 9, 7203–7208. [Google Scholar] [CrossRef]
- Perez, G.R.M.; Avila, A.J.G.; Perez, G.S.; Martinez, C.A.; Martinez, C.G. Antimicrobial Activity of Some American Algae. J. Ethnopharmacol. 1990, 29, 111–116. [Google Scholar] [CrossRef]
- Val, A.; Platas, G.; Basilio, A.; Cabello, A.; Gorrochategui, J.; Suay, I.; Vicente, F.; Portillo, E.; Río, M.; Reina, G.; et al. Screening of Antimicrobial Activities in Red, Green and Brown Macroalgae from Gran Canaria (Canary Islands, Spain). Int. Microbiol. 2001, 4, 35–40. [Google Scholar] [CrossRef] [PubMed]
- Burkholder, P.; Burkholder, L.; Almodovar, L. Antibiotic Activity of Some Marine Algae of Puerto Rico. Bot. Mar. 1960, 149–156. [Google Scholar] [CrossRef]
- Newton, L. The Production of Antibiotic Substances by Seaweeds. Phycol. Bull. 1956, 49–54. [Google Scholar]
- Kumar, S.R.; Ramanathan, G.; Subhakaran, M.; Inbaneson, S.J. Antimicrobial Compounds from Marine Halophytes for Silkworm Disease Treatment. Int. J. Med. Med. Sci. 2009, 1, 184–191. [Google Scholar] [CrossRef]
- Desbois, A.P.; Smith, V.J. Antibacterial Free Fatty Acids: Activities, Mechanisms of Action and Biotechnological Potential. Appl. Microbiol. Biotechnol. 2010, 85, 1629–1642. [Google Scholar] [CrossRef] [PubMed]
- Gupta, S.; Abu-Ghannam, N. Recent Developments in the Application of Seaweeds or Seaweed Extracts as a Means for Enhancing the Safety and Quality Attributes of Foods. Innov. Food Sci. Emerg. Technol. 2011, 12, 600–609. [Google Scholar] [CrossRef]
- Kamenarska, Z.; Stefanov, K.; Dimitrova-Konaklieva, S.; Najdenski, H.; Tsvetkova, I.; Popov, S. Chemical Composition and Biological Activity of the Brackish-Water Green Alga Cladophora rivularis (L.) Hoek. Botanica Marina. 2004, 47, 215–221. [Google Scholar] [CrossRef]
- Laungsuwon, R.; Chulalaksananukul, W. Chemical Composition and Antibacterial Activity of Extracts from Freshwater Green Algae, Cladophora Glomerata Kützing and Microspora Floccosa (Vaucher) Thuret. J. Biosci. Biotechnol. 2014, 3, 211–218. [Google Scholar]
- Stabili, L.; Acquaviva, M.I.; Biandolino, F.; Cavallo, R.A.; De Pascali, S.A.; Fanizzi, F.P.; Narracci, M.; Cecere, E.; Petrocelli, A. Biotechnological Potential of the Seaweed Cladophora Rupestris (Chlorophyta, Cladophorales) Lipidic Extract. New Biotechnol. 2014, 31, 436–444. [Google Scholar] [CrossRef] [PubMed]
- Alshuniaber, M.A.; Krishnamoorthy, R.; AlQhtani, W.H. Antimicrobial Activity of Polyphenolic Compounds from Spirulina against Food-Borne Bacterial Pathogens. Saudi J. Biol. Sci. 2021, 28, 459–464. [Google Scholar] [CrossRef]
- Piette, A.; Verschraegen, G. Role of Coagulase-Negative Staphylococci in Human Disease. Vet. Microbiol. 2009, 134, 45–54. [Google Scholar] [CrossRef] [PubMed]
- Barros, E.M.; Ceotto, H.; Bastos, M.C.F.; dos Santos, K.R.N.; Giambiagi-deMarval, M. Staphylococcus Haemolyticus as an Important Hospital Pathogen and Carrier of Methicillin Resistance Genes. J. Clin. Microbiol. 2012, 50, 166–168. [Google Scholar] [CrossRef]
- Chiew, Y.-F.; Charles, M.; Johnstone, M.C.; Thompson, K.M.; Parnell, K.D.; Penno, E.C. Detection of Vancomycin Heteroresistant Staphylococcus Haemolyticus and Vancomycin Intermediate Resistant Staphylococcus Epidermidis by Means of Vancomycin Screening Agar. Pathology 2007, 39, 375–377. [Google Scholar] [CrossRef]
- Moura, G.S.; Mota, R.A.; Marques, M.F.S.; Abad, A.C.A.; Costa, L.B.B.C.; Souza, F.N.; Almeida, V.M.; Filho, G.B.S.; Bom, H.A.S.C.; Klaumann, F.; et al. Gangrenous Mastitis in Sheep Caused by Multidrug-Resistant Staphylococcus Haemolyticus. Pesqui. Veterinária Bras. 2021, 40, 947–954. [Google Scholar] [CrossRef]
- Menteş, Ö.; Ercan, R.; Akçelik, M. Inhibitor Activities of Two Lactobacillus Strains, Isolated from Sourdough, against Rope-Forming Bacillus Strains. Food Control 2007, 18, 359–363. [Google Scholar] [CrossRef]
- Sandulachi, E.; Bulgaru, V.; Ghendov-Mosanu, A.; Sturza, R. Controlling the Risk of Bacillus in Food Using Berries. Food Nutr. Sci. 2021, 12, 557–577. [Google Scholar] [CrossRef]
- Han, K.; Jung, E.-G.; Kwon, H.-J.; Patnaik, B.B.; Baliarsingh, S.; Kim, W.-J.; Nam, K.-W.; Lee, J.-S.; Han, M.-D.; Kang, S.W. Gene Expression Analysis of Inflammation-Related Genes in Macrophages Treated with α-(1 → 3, 1 → 6)-D-Glucan Extracted from Streptococcus Mutans. Int. J. Biol. Macromol. 2021, 166, 45–53. [Google Scholar] [CrossRef]
- Jang, H.J.; Kim, J.H.; Lee, N.-K.; Paik, H.-D. Inhibitory Effects of Lactobacillus Brevis KU15153 against Streptococcus Mutans KCTC 5316 Causing Dental Caries. Microb. Pathog. 2021, 157, 104938. [Google Scholar] [CrossRef]
- Yue, J.; Yang, H.; Liu, S.; Song, F.; Guo, J.; Huang, C. Influence of Naringenin on the Biofilm Formation of Streptococcus Mutans. J. Dent. 2018, 76, 24–31. [Google Scholar] [CrossRef]
- Lim, S.-M.; Lee, N.-K.; Kim, K.-T.; Paik, H.-D. Probiotic Lactobacillus Fermentum KU200060 Isolated from Watery Kimchi and Its Application in Probiotic Yogurt for Oral Health. Microb. Pathog. 2020, 147, 104430. [Google Scholar] [CrossRef]
- Balasubramanian, A.R.; Vasudevan, S.; Shanmugam, K.; Lévesque, C.M.; Solomon, A.P.; Neelakantan, P. Combinatorial Effects of Trans-Cinnamaldehyde with Fluoride and Chlorhexidine on Streptococcus Mutans. J. Appl. Microbiol. 2021, 130, 382–393. [Google Scholar] [CrossRef]
- Ajaegbu, E.E.; Ezeh, C.U.; Dieke, A.J.; Onuora, A.L.; Ugochukwu, J.I. Antimicrobial Efficacy of Toothpastes Containing Fluoride against Clinically Isolated Streptococci Mutans. Adv. Res. 2020, 19–24. [Google Scholar] [CrossRef]
- Lim, S.-M.; Lee, N.-K.; Paik, H.-D. Antibacterial and Anticavity Activity of Probiotic Lactobacillus Plantarum 200661 Isolated from Fermented Foods against Streptococcus Mutans. LWT 2020, 118, 108840. [Google Scholar] [CrossRef]
- Nakamura, E.; Yokota, H.; Matsui, T. The in Vitro Digestibility and Absorption of Magnesium in Some Edible Seaweeds. J. Sci. Food Agric. 2012, 92, 2305–2309. [Google Scholar] [CrossRef]
- World Health Organization; Agency, I.A.E. Nations, Food and Agriculture Organization of the U. Trace Elements in Human Nutrition and Health; World Health Organization: Geneva, Switzerland, 1996. [Google Scholar]
- Waheed, M.; Butt, M.S.; Shehzad, A.; Adzahan, N.M.; Shabbir, M.A.; Rasul Suleria, H.A.; Aadil, R.M. Eggshell Calcium: A Cheap Alternative to Expensive Supplements. Trends Food Sci. Technol. 2019, 91, 219–230. [Google Scholar] [CrossRef]
- Rzymski, P.; Budzulak, J.; Niedzielski, P.; Klimaszyk, P.; Proch, J.; Kozak, L.; Poniedziałek, B. Essential and Toxic Elements in Commercial Microalgal Food Supplements. J. Appl. Phycol. 2019, 31, 3567–3579. [Google Scholar] [CrossRef]
- Thompson, M.E.H.; Raizada, M.N. Fungal Pathogens of Maize Gaining Free Passage Along the Silk Road. Pathogens 2018, 7, 81. [Google Scholar] [CrossRef] [PubMed]
- Scientific Opinion on Dietary Reference Values for Manganese. EFSA J. 2013, 11, 3419. [CrossRef]
- EFSA Scientific Opinion on the Use of Cobalt Compounds as Additives in Animal Nutrition. EFSA J. 2009, 7, 1383. [CrossRef]
- World Health Organization, Regional Office for Europe. Air Quality Guidelines for Europe, 2nd ed.; World Health Organization, Regional Office for Europe: Geneva, Switzerland, 2000; ISBN 978-92-890-1358-1. [Google Scholar]
- García-Casal, M.N.; Pereira, A.C.; Leets, I.; Ramírez, J.; Quiroga, M.F. High Iron Content and Bioavailability in Humans from Four Species of Marine Algae. J. Nutr. 2007, 137, 2691–2695. [Google Scholar] [CrossRef] [PubMed]
- European Food Safety Authority. Tolerable Upper Intake Levels for Vitamins and Minerals; European Food Safety Authority, Ed.; European Food Safety Authority: Parma, Italy, 2006; ISBN 978-92-9199-014-6. [Google Scholar]
- Institute of Medicine (US) Panel on Micronutrients. Dietary Reference Intakes for Vitamin A, Vitamin K, Arsenic, Boron, Chromium, Copper, Iodine, Iron, Manganese, Molybdenum, Nickel, Silicon, Vanadium, and Zinc; National Academies Press (US): Washington, DC, USA, 2001; ISBN 978-0-309-07279-3. [Google Scholar]
- Desideri, D.; Cantaluppi, C.; Ceccotto, F.; Meli, M.A.; Roselli, C.; Feduzi, L. Essential and Toxic Elements in Seaweeds for Human Consumption. J. Toxicol. Environ. Health A 2016, 79, 112–122. [Google Scholar] [CrossRef]
- Burger, J.; Gochfeld, M.; Jeitner, C.; Donio, M.; Pittfield, T. Lead (Pb) in Biota and Perceptions of Pb Exposure at a Recently Designated Superfund Beach Site in New Jersey. J. Toxicol. Environ. Health A 2012, 75, 272–287. [Google Scholar] [CrossRef]
- Hwang, Y.O.; Park, S.G.; Park, G.Y.; Choi, S.M.; Kim, M.Y. Total Arsenic, Mercury, Lead, and Cadmium Contents in Edible Dried Seaweed in Korea. Food Addit. Contam. Part B Surveill. 2010, 3, 7–13. [Google Scholar] [CrossRef]
- Feldmann, J.; Krupp, E.M. Critical Review or Scientific Opinion Paper: Arsenosugars—A Class of Benign Arsenic Species or Justification for Developing Partly Speciated Arsenic Fractionation in Foodstuffs? Anal. Bioanal. Chem. 2011, 399, 1735–1741. [Google Scholar] [CrossRef] [PubMed]
- Commission Regulations Commission Regulation (EC) No 1881/2006 of 19 December 2006 Setting Maximum Levels for Certain Contaminants in Foodstuffs (Text with EEA Relevance). Available online: https://www.legislation.gov.uk/eur/2006/1881 (accessed on 21 January 2021).
- Anna, F.; Lubecki, L.; Szymczak-Żyła, M.; Kowalewska, G.; Radosław, Ż.; Piotr, S. Utilisation of Macroalgae from the Sopot Beach (Baltic Sea). Oceanologia 2008, 50, 255–273. [Google Scholar]
- Commission Directive 2002/32/EC EUR-Lex—32002L0032—EN—EUR-Lex. Available online: https://eur-lex.europa.eu/legal-content/EN/ALL/?uri=CELEX%3A32002L0032 (accessed on 2 February 2021).
- Papazi, A.; Makridis, P.; Divanach, P. Harvesting Chlorella Minutissima Using Cell Coagulants. J. Appl. Phycol. 2010, 22, 349–355. [Google Scholar] [CrossRef]
- Rzymski, P.; Niedzielski, P.; Kaczmarek, N.; Jurczak, T.; Klimaszyk, P. The Multidisciplinary Approach to Safety and Toxicity Assessment of Microalgae-Based Food Supplements Following Clinical Cases of Poisoning. Harmful Algae 2015, 46, 34–42. [Google Scholar] [CrossRef]

| Algal Extract Sample | Colour Coordinates, NBS | ||||||
|---|---|---|---|---|---|---|---|
| Algal Extract Samples | Lyophilised Algal Samples | ||||||
| a* | b* | L* | a* | b* | L* | ||
| Macroalgae | Cla | −8.67 ± 0.19 b,C | 16.21 ± 0.11 c,C | 32.06 ± 0.25 a,A | −1.60 ± 0.02 b,E | 5.09 ± 0.04 b,C | 47.66 ± 0.20 a,C |
| Furc | −5.49 ± 0.14 c,E | 14.38 ± 0.13 a,A | 50.19 ± 0.31 c,F | 1.32 ± 0.03 c,F | 4.49 ± 0.03 a,B | 47.54 ± 0.15 a,C | |
| Ul | −9.68 ± 0.16 a,B | 28.87 ± 0.16 f,F | 42.04 ± 0.27 b,C | −3.52 ± 0.02 a,D | 11.08 ± 0.10 c,D | 47.75 ± 0.17 a,C | |
| Microalgae | Chlo | −7.97 ± 0.12 b,D | 23.08 ± 0.19 e,E | 46.61 ± 0.25 b,D | −7.93 ± 0.11 a,A | 27.29 ± 0.03 c,F | 43.93 ± 0.19 b,B |
| Sp1 | −2.10 ± 0.09 c,F | 21.93 ± 0.18 d,D | 47.07 ± 0.19 c,E | −5.49 ± 0.04 c,C | 14.38 ± 0.11 b,E | 50.19 ± 0.23 c,D | |
| Sp2 | −13.41 ± 0.14 a,A | 15.47 ± 0.13 b,B | 37.40 ± 0.21 a,B | −6.56 ± 0.05 b,B | 1.83 ± 0.13 a,A | 39.98 ± 0.18 a,A | |
| Algal Extract Sample | Pathogenic and Opportunistic Bacteria Strains | |||||||||
|---|---|---|---|---|---|---|---|---|---|---|
| Escherichiacoli | Klebsiella pneumonia | Salmonella enterica | Cronobacter sakazakii | Acinetobacter baumani | Pseudomona aeruginosa | Staphylococcus aureus | Staphylococcus haemolyticus | Bacillus subtilis | Streptococcus mutans | |
| Inhibition zones by using the agar well diffusion, mm | ||||||||||
| Cla | nd | nd | nd | nd | nd | nd | nd | nd | 12.0 ± 0.3 | nd |
| Furc | nd | nd | nd | nd | nd | nd | nd | nd | 8.0 ± 0.2 | nd |
| Ul | nd | nd | nd | nd | nd | nd | nd | nd | 17.0 ± 0.4 | 14.2 ± 0.2 |
| Chlo | nd | nd | nd | nd | nd | nd | nd | nd | nd | nd |
| Sp1 | nd | nd | nd | nd | nd | nd | nd | 28.3 ± 0.7 | 10.1 ± 0.5 | nd |
| Sp2 | nd | nd | nd | nd | nd | nd | nd | nd | nd | nd |
| Antimicrobial activity of the algal extracts in liquid medium | ||||||||||
| Concentration of algae extract 10 µL, concentration of pathogen 10 µL | ||||||||||
| Cla | + | + | + | + | + | + | + | + | + | + |
| Furc | + | + | + | + | + | + | + | + | + | + |
| Ul | + | + | + | + | + | + | + | + | + | + |
| Chlo | + | + | + | + | + | + | + | + | + | + |
| Sp1 | + | + | + | + | + | + | + | + | + | + |
| Sp2 | + | + | + | + | + | + | + | + | + | + |
| Concentration of algae extract 50 µL, concentration of pathogen 10 µL | ||||||||||
| Cla | + | + | + | + | + | + | + | + | + | + |
| Furc | + | + | + | + | + | + | + | + | + | + |
| Ul | + | + | + | + | + | + | + | + | + | + |
| Chlo | + | + | + | + | + | + | + | + | + | + |
| Sp1 | + | + | + | + | + | + | + | + | + | + |
| Sp2 | + | + | + | + | + | + | + | + | + | + |
| Concentration of algae extract 100 µL, concentration of pathogen 10 µL | ||||||||||
| Cla | + | + | + | + | + | + | + | + | + | + |
| Furc | + | + | + | + | + | + | + | + | + | + |
| Ul | + | + | + | + | + | + | + | + | + | + |
| Chlo | + | + | + | + | + | + | + | + | + | + |
| Sp1 | + | + | + | + | + | + | + | + | + | + |
| Sp2 | + | + | + | + | + | + | + | + | + | + |
| Concentration of algae extract 500 µL, concentration of pathogen 10 µL | ||||||||||
| Cla | + | + | + | + | + | + | + | + | + | + |
| Furc | + | + | + | + | + | + | + | + | + | + |
| Ul | + | + | + | + | + | + | + | + | + | + |
| Chlo | + | + | + | + | + | + | + | + | + | + |
| Sp1 | + | + | + | + | + | + | + | + | + | + |
| Sp2 | + | + | + | + | + | + | + | + | + | + |
| Pathogen control | ||||||||||
| Pathogen | + | + | + | + | + | + | + | + | + | + |
| Trace Element | Algal Extract Samples | |||||
|---|---|---|---|---|---|---|
| Macroalgae | Microalgae | |||||
| Cla | Furc | Ul | Chlo | Sp1 | Sp2 | |
| Macro-elements, mg kg−1 d.m. | ||||||
| Na | 220 ± 13 a,C | 277 ± 11 b,D | 517 ± 25 c,F | 27.1 ± 1.3 a,A | 136 ± 6 b,B | 458 ± 18 c,E |
| Mg | 140 ± 9 a,D | 206 ± 14 b,E | 259 ± 14 c,F | 11.7 ± 0.9 a,A | 15.5 ± 1.1 b,B | 51.0 ± 3.2 c,C |
| K | 975 ± 32 c,E | 445 ± 21 b,D | 336 ± 19 a,C | 77 ± 4 a,A | 110 ± 5 b,B | 950 ± 29 c,E |
| Ca | 40.2 ± 3.1 b,E | 68.3 ± 4.2 c,F | 18.8 ± 0.7 a,C | 2.36 ± 0.14 a,A | 7.17 ± 0.16 b,B | 29.1 ± 1.7 c,D |
| Essential microelements, mg kg−1 d.m. | ||||||
| Cr | 0.003 ± 0.001 a,A | 0.042 ± 0.003 c,C | 0.023 ± 0.002 b,B | 0.002 ± 0.001 a,A | 0.005 ± 0.002 a,A | 0.056 ± 0.004 b,D |
| Mn | 7.41 ± 0.52 c,F | 1.10 ± 0.07 b,E | 0.435 ± 0.021 a,D | 0.028 ± 0.002 a,A | 0.063 ± 0.004 b,B | 0.333 ± 0.021 c,C |
| Fe | 4.34 ± 0.31 c,E | 2.66 ± 0.19 b,D | 1.09 ± 0.08 a,A | 2.25 ± 0.011 b,C | 1.37 ± 0.009 a,B | 4.73 ± 0.15 c,E |
| Co | 0.064 ± 0.005 d,D | 0.003 ± 0.001 a,A | 0.006 ± 0.001 b,B | 0.002 ± 0.001 a,A | 0.002 ± 0.001 a,A | 0.040 ± 0.003 c,C |
| Ni | 0.301 ± 0.011 c,D | 0.015 ± 0.002 b,B | 0.005 ± 0.001 a,A | nd | nd | 0.020 ± 0.001 C |
| Cu | 0.101 ± 0.009 b,D | 0.004 ± 0.001 a,A | 0.202 ± 0.013 c,E | 0.077 ± 0.003 b,C | 0.020 ± 0.002 a,B | 0.071 ± 0.005 b,C |
| Se | 0.004 ± 0.002 a,A | 0.001 ± 0.001 a,A | 0.002 ± 0.001 a,A | nd | nd | 0.004 ± 0.002 A |
| Non-essential microelements, mg kg−1 d.m. | ||||||
| As | 0.334 ± 0.021 b,D | 0.255 ± 0.016 a,C | 0.437 ± 0.031 c,E | 0.004 ± 0.002 a,A | 0.002 ± 0.001 a,A | 0.022 ± 0.002 b,B |
| V | 0.006 ± 0.001 a,B | 0.004 ± 0.001 a,A,B | 0.004 ± 0.001 a,A,B | 0.001 ± 0.001 a,A | nd | 0.002 ± 0.001 a,A |
| Rb | 0.507 ± 0.026 c,F | 0.252 ± 0.017 b,E | 0.140 ± 0.009 a,C | 0.020 ± 0.001 b,B | 0.010 ± 0.001 a,A | 0.181 ± 0.012 c,D |
| Sr | 0.398 ± 0.014 b,E | 0.621 ± 0.035 c,F | 0.245 ± 0.011 a,C | 0.017 ± 0.002 a,A | 0.060 ± 0.003 b,B | 0.346 ± 0.019 c,D |
| Mo | nd | 0.004 ± 0.001 a,A | 0.007 ± 0.001 b,B | nd | 0.004 ± 0.001 a,A | 0.010 ± 0.001 b,C |
| Ag | 0.018 ± 0.001 a,A | 0.098 ± 0.007 c,C | 0.029 ± 0.002 b,B | nd | 0.034 ± 0.003 a,B | 0.164 ± 0.013 b,D |
| Sb | 0.046 ± 0.003 b,C | 0.005 ± 0.001 a,A | 0.163 ± 0.007 c,E | nd | 0.032 ± 0.003 a,B | 0.098 ± 0.008 b,D |
| Cs | nd | 0.001 ± 0.000 | nd | nd | nd | nd |
| Ti | nd | nd | nd | nd | nd | 0.001 ± 0.000 |
| Cd | nd | nd | nd | nd | nd | 0.001 ± 0.000 |
| Ba | 0.032 ± 0.002 b,C | 0.033 ± 0.002 b,C | 0.008 ± 0.001 a,B | 0.001 ± 0.000 a,A | 0.006 ± 0.001 b,B | 0.043 ± 0.003 c,D |
| Pb | 0.002 ± 0.001 a,A | 0.003 ± 0.001 a,b,A,B | 0.001 ± 0.000 a,A | 0.001 ± 0.000 a,A | 0.001 ± 0.000 a,A | 0.002 ± 0.001 a,A |
| Al | 0.343 ± 0.018 b,B | 1.14 ± 0.01 c,C | 0.111 ± 0.009 a,A | nd | nd | 1.15 ± 0.009 C |
| Li | 0.013 ± 0.002 a,B | 0.023 ± 0.002 b,C | 0.047 ± 0.003 c,D | 0.002 ± 0.001 a,A | 0.005 ± 0.002 a,A | 0.070 ± 0.006 b,E |
Publisher’s Note: MDPI stays neutral with regard to jurisdictional claims in published maps and institutional affiliations. |
© 2021 by the authors. Licensee MDPI, Basel, Switzerland. This article is an open access article distributed under the terms and conditions of the Creative Commons Attribution (CC BY) license (https://creativecommons.org/licenses/by/4.0/).
Share and Cite
Tolpeznikaite, E.; Bartkevics, V.; Ruzauskas, M.; Pilkaityte, R.; Viskelis, P.; Urbonaviciene, D.; Zavistanaviciute, P.; Zokaityte, E.; Ruibys, R.; Bartkiene, E. Characterization of Macro- and Microalgae Extracts Bioactive Compounds and Micro- and Macroelements Transition from Algae to Extract. Foods 2021, 10, 2226. https://doi.org/10.3390/foods10092226
Tolpeznikaite E, Bartkevics V, Ruzauskas M, Pilkaityte R, Viskelis P, Urbonaviciene D, Zavistanaviciute P, Zokaityte E, Ruibys R, Bartkiene E. Characterization of Macro- and Microalgae Extracts Bioactive Compounds and Micro- and Macroelements Transition from Algae to Extract. Foods. 2021; 10(9):2226. https://doi.org/10.3390/foods10092226
Chicago/Turabian StyleTolpeznikaite, Ernesta, Vadims Bartkevics, Modestas Ruzauskas, Renata Pilkaityte, Pranas Viskelis, Dalia Urbonaviciene, Paulina Zavistanaviciute, Egle Zokaityte, Romas Ruibys, and Elena Bartkiene. 2021. "Characterization of Macro- and Microalgae Extracts Bioactive Compounds and Micro- and Macroelements Transition from Algae to Extract" Foods 10, no. 9: 2226. https://doi.org/10.3390/foods10092226
APA StyleTolpeznikaite, E., Bartkevics, V., Ruzauskas, M., Pilkaityte, R., Viskelis, P., Urbonaviciene, D., Zavistanaviciute, P., Zokaityte, E., Ruibys, R., & Bartkiene, E. (2021). Characterization of Macro- and Microalgae Extracts Bioactive Compounds and Micro- and Macroelements Transition from Algae to Extract. Foods, 10(9), 2226. https://doi.org/10.3390/foods10092226

